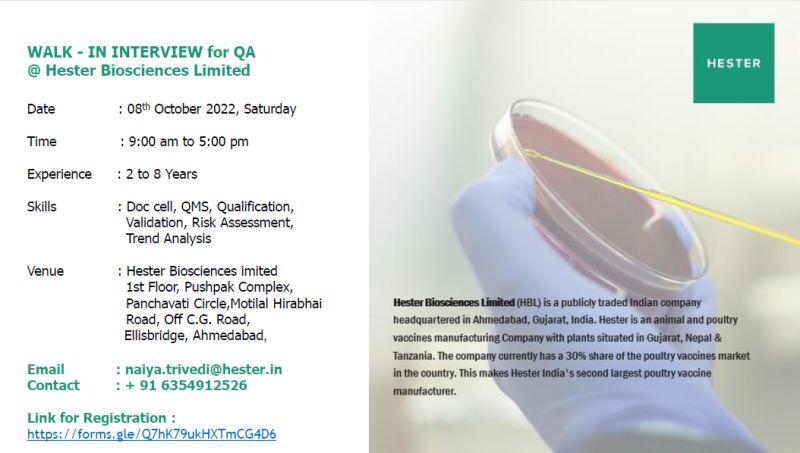

WALK-IN INTERVIEW for QA on 08th October 2022 @Hester Biosciences Limited
Walk in Interview for QA on 08/10/2022 @ Ahmedabad
Date : 08th October 2022, Saturday
Time : 9:00 am to 5:00 pm
Experience : 2 to 8 Years
Skills : Doc cell, QMS, Qualification, Validation, Risk Assessment, Trend Analysis
Experience : 2 to 8 Years
Education : B.Pharma/M.Pharma/M.sc (Biotechnology/Microbiology)
Venue : Hester Biosciences limited
1st Floor, Pushpak Complex, Panchavati Circle,Motilal Hirabhai Road, Off C.G. Road, Ellisbridge, Ahmedabad
Registration Link : https://lnkd.in/dgiaurHB

India's DMPLOI - Jobs & Networking App